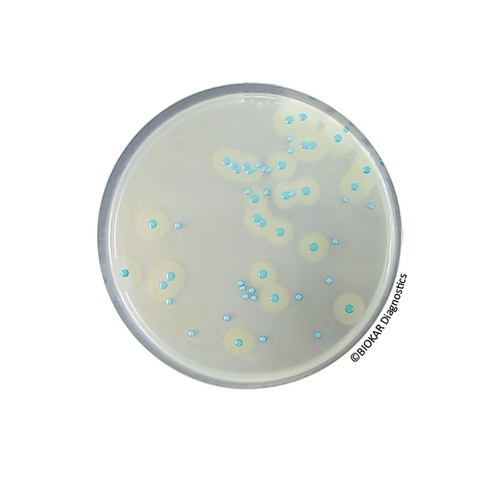

COMPASS® Listeria Agar
COMPASS® Listeria constitutes a method constitutes a method for the detection of Listeria monocytogenes and of Listeria spp, and a method for the enumeration of Listeria monocytogenes in food products, and in environmental samples even heavily contaminated. The method COMPASS® Listeria is used in the context of the alternative rapid method of detection of L. monocytogenes, in human food products and environmental samples. It is characterized by one sole step in selective enrichment ½ Fraser broth, followed by a re-inoculation onto COMPASS Listeria Agar. The method is certified NF VALIDATION, under the reference N° BKR 23/02-11/02. The method COMPASS® Listeria agar can also be used within the context of the alternative rapid method of enumeration of L. monocytogenes for all human foods and for environmental samples, by inoculation of one plate either on the surface or as a pour plate. It is officially certified by AFNOR Certification, under the reference number BKR 23/05-12/07.
| Ürün Adı | COMPASS® Listeria Agar Enrichment Supplement - liquid |
| Ürün Kodu | BS07008 |
| Miktar | 8 vials qsp 1L |
| Ürün Adı | COMPASS® Listeria Agar Selective Supplement - liquid |
| Ürün Kodu | BS07108 |
| Miktar | 8 vials qsp 1L |
| Ürün Adı | COMPASS® Listeria Agar |
| Ürün Kodu | BK192HA |
| Miktar | 500 g |
| Ürün Adı | COMPASS® Listeria Agar |
| Ürün Kodu | BM12408 |
| Miktar | 120 Petri plates Ø 90 mm |
| Ürün Adı | COMPASS® Listeria Agar |
| Ürün Kodu | BT00808 |
| Miktar | 6 vials of 200 mL |
| Ürün Adı | COMPASS® Listeria Agar |
| Ürün Kodu | BM12308 |
| Miktar | 20 Petri plates Ø 90 mm |